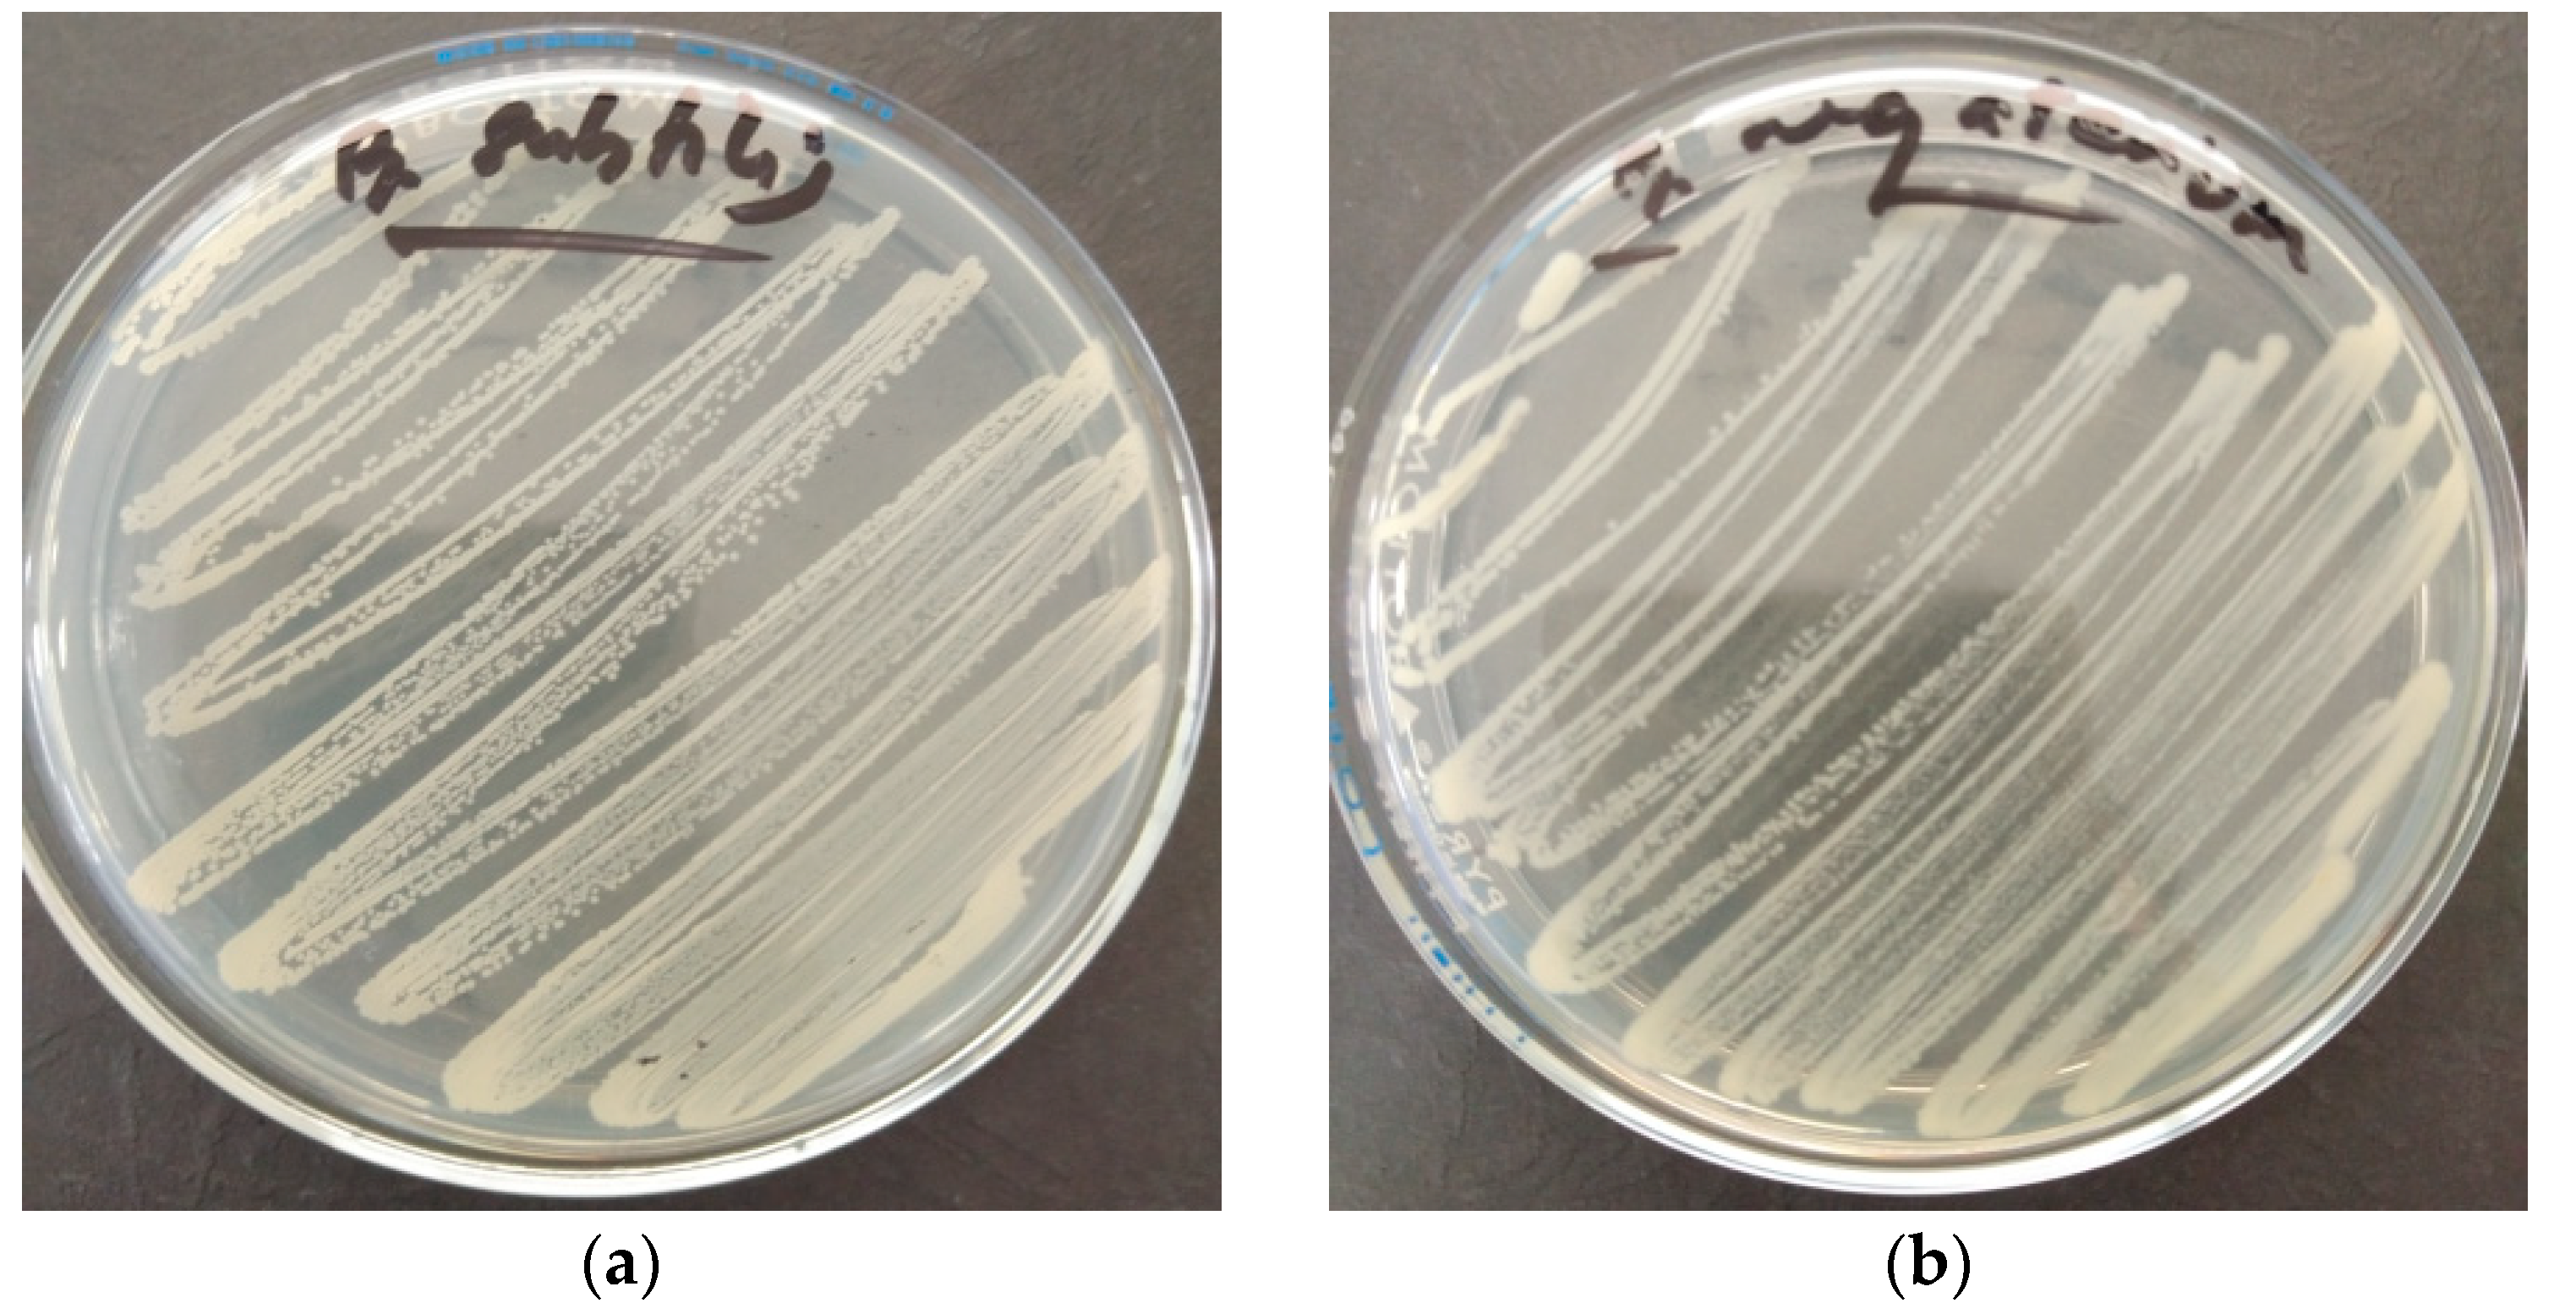

Exploring the Potential of Polypropylene Fibers and Bacterial Co-Culture in Repairing and Strengthening Geopolymer-Based Construction Materials †
Abstract
1. Introduction
2. Materials and Methods
2.1. Materials
2.2. Preparation of Geopolymer Samples
2.3. Bacterial Culture Maintenance and Spore Induction Assay
2.4. pH and Temperature Tolerance Assay
2.5. Test Procedure
2.5.1. Ultrasonic Pulse Velocity (UPV)
2.5.2. Compressive Strength
2.5.3. Microstructural Observation
3. Results and Discussion
3.1. pH and Temperature Tolerance
3.2. Compressive Strength
3.3. Ultrasonic Pulse Velocity (UPV)
3.4. Material Characterization
4. Conclusions and Recommendations
- Geopolymer mortar containing polypropylene and bacteria has the potential to be utilized as a non-structural and aesthetic repair material due to its compressive strength of at least 15 MPa, whereas the combination of geopolymer and polypropylene fiber has the potential to be employed as a structural repair material in severe environments.
- Increasing the amount of polypropylene fiber would increase the contact area of the fiber with the geopolymer matrix, which can minimize crack propagation and enhance the strength-regain ratio of the geopolymer material. Meanwhile, the strength-regain percentage of the inoculated geopolymer is 11.22% higher than that of the non-inoculated geopolymer. This only shows that the inclusion of bacteria can improve the strength-regain value of the geopolymer mortar through the process of mineral precipitation. The inclusion of 0.75% polypropylene fiber in the geopolymer mortar with bacteria had a strength-regain percentage value of 199.97%.
- For the damage degree and self-healing percentages, polypropylene with bacteria has a significant effect on minimizing the damage degree and improving the healing percentages of geopolymer mortar. It is worth noting that only geopolymers containing bacteria have shown positive self-healing percentages, ranging from 16.77% to 147.18%.
- The results of the SEM-EDX and XRF revealed that the amount of calcite crystals was more evident in the bacterial samples than in the samples without bacteria, which resulted in an increase in the strength-regain ratio and self-healing percentages.
- A two-way ANOVA revealed that there was no statistically significant interaction between the effects of the polypropylene fiber and the presence of bacteria. However, co-culturing of bacteria and polypropylene has a significant effect on the compressive strength of the geopolymer mortar.
Author Contributions
Funding
Data Availability Statement
Acknowledgments
Conflicts of Interest
Abbreviations
| AA | Alkaline activator |
| ANOVA | Analysis of variance |
| ASTM | American Society for Testing and Materials |
| BLAST | Basic Local Alignment Search Tool |
| CBA | Coal bottom ash |
| CI | Confidence interval |
| CoV | Coefficient of variation |
| CSH | Calcium silicate hydrate |
| DOE | Design of experiment |
| FRCC | Fiber-reinforced cementitious composites |
| GBS | Granulated blast furnace slag |
| GGBS | Ground granulated blast furnace slag |
| GPC | Geopolymer concrete |
| KOH | Potassium hydroxide |
| MPa | Megapascal |
| NA | Nutrient agar |
| NB | Nutrient broth |
| OPC | Ordinary Portland cement |
| PCC | Portland cement concrete |
| PP | Polypropylene |
| PPF | Polypropylene fiber |
| PPI | Pozzolanic Philippines Inc |
| RNA | Ribosomal ribonucleic acid |
| SEM | Scanning electron microscope |
| UCS | Unconfined compressive strength |
| UPLB | University of the Philippines Los Banos |
| UPV | Ultrasonic pulse velocity |
| XRF | X-ray fluorescence |
References
- Worrell, E.; Price, L.; Martin, N.; Hendriks, C.; Meida, L.O. Carbon Dioxide Emissions from the Global Cement Industry. Annu. Rev. Energy Environ. 2001, 26, 303–329. [Google Scholar] [CrossRef]
- Zhou, W.; Yan, C.; Duan, P.; Liu, Y.; Zhang, Z.; Qiu, X.; Li, D. A comparative study of high-and low-Al2O3 fly ash based-geopolymers: The role of mix proportion factors and curing temperature. Mater. Des. 2016, 95, 63–74. [Google Scholar] [CrossRef]
- Robayo-Salazar, R.; Mejía-Arcila, J.; Mejía de Gutiérrez, R.; Martínez, E. Life cycle assessment (LCA) of an alkali-activated binary concrete based on natural volcanic pozzolan: A comparative analysis to OPC concrete. Constr. Build. Mater. 2018, 176, 103–111. [Google Scholar] [CrossRef]
- Maddalena, R.; Roberts, J.J.; Hamilton, A. Can Portland cement be replaced by low-carbon alternative materials? A study on the thermal properties and carbon emissions of innovative cements. J. Clean. Prod. 2018, 186, 933–942. [Google Scholar] [CrossRef]
- Duxson, P.; Provis, J.L.; Lukey, G.C.; Van Deventer, J.S.J. The role of inorganic polymer technology in the development of “green concrete”. Cem. Concr. Res. 2007, 37, 1590–1597. [Google Scholar] [CrossRef]
- Hassan, A.; Arif, M.; Shariq, M. Mechanical Behaviour and Microstructural Investigation of Geopolymer Concrete after Exposure to Elevated Temperatures. Arab. J. Sci. Eng. 2019, 45, 3843–3861. [Google Scholar] [CrossRef]
- Yao, X.; Shamsaei, E.; Wang, W.; Zhang, S.; Sagoe-Crentsil, K.; Duan, W. Graphene-based modification on the interface in fibre reinforced cementitious composites for improving both strength and toughness. Carbon 2020, 170, 493–502. [Google Scholar] [CrossRef]
- Samal, S.; Phan Thanh, N.; Petríková, I.; Marvalová, B. Improved Mechanical Properties of Various Fabric-Reinforced Geocomposite at Elevated Temperature. JOM J. Miner. Met. Mater. Soc. 2015, 67, 1478–1485. [Google Scholar] [CrossRef]
- Larsen, I.L.; Thorstensen, R.T. The influence of steel fibres on compressive and tensile strength of ultra high performance concrete: A review. Constr. Build. Mater. 2020, 256, 119459. [Google Scholar] [CrossRef]
- Zhang, Z.; Yao, X.; Zhu, H.; Hua, S.; Chen, Y. Preparation and mechanical properties of polypropylene fiber reinforced calcined kaolin-fly ash based geopolymer. J. Cent. South Univ. Technol. 2009, 16, 49–52. [Google Scholar] [CrossRef]
- Ranjbar, N.; Mehrali, M.; Behnia, A.; Javadi Pordsari, A.; Mehrali, M.; Alengaram, U.J.; Jumaat, M.Z. A Comprehensive Study of the Polypropylene Fiber Reinforced Fly Ash Based Geopolymer. PLoS ONE 2016, 11, e0147546. [Google Scholar] [CrossRef] [PubMed]
- Mohseni, E. Assessment of Na2SiO3 to NaOH ratio impact on the performance of polypropylene fiber-reinforced geopolymer composites. Constr. Build. Mater. 2018, 186, 904–911. [Google Scholar] [CrossRef]
- Chindaprasirt, P.; Rattanasak, U. Synthesis of polypropylene fiber/high-calcium fly ash geopolymer with outdoor heat exposure. Clean Technol. Environ. Policy 2017, 19, 1985–1992. [Google Scholar] [CrossRef]
- Khaliq, W.; Ehsan, M.B. Crack healing in concrete using various bio influenced self-healing techniques. Constr. Build. Mater. 2016, 102, 349–357. [Google Scholar] [CrossRef]
- De Koster, S.A.L.; Mors, R.M.; Nugteren, H.W.; Jonkers, H.M.; Meesters, G.M.H.; van Ommen, J.R. Geopolymer Coating of Bacteria-containing Granules for Use in Self-healing Concrete. Procedia Eng. 2015, 102, 475–484. [Google Scholar] [CrossRef]
- Jadhav, U.U.; Lahoti, M.; Chen, Z.; Qiu, J.; Cao, B.; Yang, E.-H. Viability of bacterial spores and crack healing in bacteria-containing geopolymer. Constr. Build. Mater. 2018, 169, 716–723. [Google Scholar] [CrossRef]
- Wulandari, K.D.; Ekaputri, J.J.; Fujiyama, C.; Setiamarga, D.H. Effects of microbial agents to the properties of fly ash-based paste. MATEC Web Conf. 2018, 195, 01012. [Google Scholar] [CrossRef][Green Version]
- Chatterjee, A.; Chattopadhyay, B.; Mandal, S. Bacterium amended 100% fly ash geopolymer. AIP Conf. Proc. 2019, 2158, 020013. [Google Scholar]
- Wulandari, K.D.; Ekaputri, J.J.; Triwulan; Kurniawan, S.B.; Primaningtyas, W.E.; Sheikh Abdullah, S.R.; Imron, M.F. Effect of microbes addition on the properties and surface morphology of fly ash-based geopolymer paste. J. Build. Eng. 2020, 33, 101596. [Google Scholar] [CrossRef]
- Chatterjee, A.; Sarkar, A.; Ghosh, S.; Mandal, S.; Chattopadhyay, B. Bacterium-incorporated fly ash geopolymer: A high-performance, thermo-stable cement alternative for future construction material. Clean Technol. Environ. Policy 2019, 21, 1779–1789. [Google Scholar] [CrossRef]
- Rautray, S.S.; Mohanty, B.N.; Das, M.R. Performance of self-compacting geopolymer concrete using Bacillus Licheniformis. Mater. Today Proc. 2020, 26, 2817–2824. [Google Scholar] [CrossRef]
- Doctolero, J.Z.S.; Beltran, A.B.; Uba, M.O.; Tigue, A.A.S.; Promentilla, M.A.B. Self-Healing Biogeopolymers Using Biochar-Immobilized Spores of Pure- and Co-Cultures of Bacteria. Minerals 2020, 10, 1114. [Google Scholar] [CrossRef]
- Tian, Z.; Tang, X.; Xiu, Z.; Zhou, H.; Xue, Z. The mechanical properties improvement of environmentally friendly fly ash-based geopolymer mortar using bio-mineralization. J. Clean. Prod. 2021, 332, 130020. [Google Scholar] [CrossRef]
- Ganesh, C.; Muthukannan, M.; Suresh Kumar, A.; Arunkumar, K. Influence of Bacterial Strain Combination in Hybrid Fiber Reinforced Geopolymer Concrete subjected to Heavy and Very Heavy Traffic Condition. J. Adv. Concr. Technol. 2021, 19, 359–369. [Google Scholar] [CrossRef]
- Tanyildizi, H.; Ziada, M.; Uysal, M.; Doğruöz Güngör, N.; Coskun, A. Comparison of bacteria-based self-healing methods in metakaolin geopolymer mortars. Case Stud. Constr. Mater. 2022, 16, e00895. [Google Scholar] [CrossRef]
- Polat, B.Y. Self healing of alkali active mortars with expanded perlite aggregate. Case Stud. Constr. Mater. 2022, 17, e01225. [Google Scholar]
- Ekinci, E.; Türkmen, I.; Birhanlı, E. Performance of self-healing geopolymer paste produced using Bacillus subtilis. Constr. Build. Mater. 2022, 325, 126837. [Google Scholar] [CrossRef]
- Ekinci, E.; Türkmen, I.; Birhanlı, E. Mechanical and durability characteristics of GGBS-based self-healing geopolymer mortar produced using by an endospore-forming bacterium. J. Build. Eng. 2022, 57, 104944. [Google Scholar] [CrossRef]
- Han, Z.; Wang, J.; Zhao, H.; Tucker, M.; Zhao, Y.; Wu, G.; Zhou, J.; Yin, J.; Zhang, H.; Zhang, X.; et al. Mechanism of Biomineralization Induced by Bacillus subtilis J2 and Characteristics of the Biominerals. Minerals 2019, 9, 218. [Google Scholar] [CrossRef]
- Kaur, G.; Dhami, N.K.; Goyal, S.; Mukherjee, A.; Reddy, M.S. Utilization of carbon dioxide as an alternative to urea in biocementation. Constr. Build. Mater. 2016, 123, 527–533. [Google Scholar] [CrossRef]
- Nocentini, A.; Capasso, C.; Supuran, C.T. Carbonic Anhydrase Inhibitors as Novel Antibacterials in the Era of Antibiotic Resistance: Where Are We Now? Antibiotics 2023, 12, 142. [Google Scholar] [CrossRef] [PubMed]
- Koltai, T.; Reshkin, S.J.; Harguindey, S. Chapter 7—Carbonic anhydrases. In An Innovative Approach to Understanding and Treating Cancer: Targeting pH; Academic Press: Cambridge, MA, USA, 2020; pp. 157–176. [Google Scholar]
- Anbu, P.; Kang, C.-H.; Shin, Y.-J.; So, J.-S. Formations of calcium carbonate minerals by bacteria and its multiple applications. SpringerPlus 2016, 5, 250. [Google Scholar] [CrossRef] [PubMed]
- Hargis, C.W.; Chen, I.A.; Devenney, M.; Fernandez, M.J.; Gilliam, R.J.; Thatcher, R.P. Calcium Carbonate Cement: A Carbon Capture, Utilization, and Storage (CCUS) Technique. Materials 2021, 14, 2709. [Google Scholar] [CrossRef] [PubMed]
- Alshaeer, H.; Irwan, J.M.; Alshalif, A.; Al-Fakih, A.; Ewais, D.; Salmi, A.; Alhokabi, A. Review on Carbonation Study of Reinforcement Concrete Incorporating with Bacteria as Self-Healing Approach. Materials 2022, 15, 5543. [Google Scholar] [CrossRef]
- ASTM C618-19; Standard Specification for Coal Fly Ash and Raw or Calcined Natural Pozzolan for Use in Concrete. ASTM International: West Conshohocken, PA, USA, 2019.
- Parthiban, K.; Saravanarajamohan, K.; Shobana, S.; Bhaskar, A.A. Effect of replacement of slag on the mechanical properties of fly ash based geopolymer concrete. Int. J. Eng. Technol. 2013, 5, 2555–2559. [Google Scholar]
- Wong, C.L.; Mo, K.H.; Alengaram, U.J.; Yap, S.P. Mechanical strength and permeation properties of high calcium fly ash-based geopolymer containing recycled brick powder. J. Build. Eng. 2020, 32, 101655. [Google Scholar] [CrossRef]
- Nagaraj, V.K.; Babu, D. Assessing the performance of molarity and alkaline activator ratio on engineering properties of self-compacting alkaline activated concrete at ambient temperature. J. Build. Eng. 2018, 20, 137–155. [Google Scholar]
- Herwani; Pane, I.; Imran, I.; Budiono, B. Compressive Strength of Fly ash-based Geopolymer Concrete with a Variable of Sodium Hydroxide (NaOH) Solution Molarity. MATEC Web Conf. 2018, 147, 01004. [Google Scholar] [CrossRef]
- Azzahran Abdullah, S.F.; Yun-Ming, L.; Al Bakri, M.M.; Cheng-Yong, H.; Zulkifly, K.; Hussin, K. Effect of Alkali Concentration on Fly Ash Geopolymers. IOP Conf. Ser. Mater. Sci. Eng. 2018, 343, 012013. [Google Scholar] [CrossRef]
- ASTM C778-13; Standard Specification for Standard Sand. ASTM International: West Conshohocken, PA, USA, 2006.
- ASTM C136/C136M-19; Standard Test Method for Sieve Analysis of Fine and Coarse Aggregates. ASTM International: West Conshohocken, PA, USA, 2019.
- Vijay, K.; Murmu, M.; Deo, S.V. Bacteria based self healing concrete—A review. Constr. Build. Mater. 2017, 152, 1008–1014. [Google Scholar] [CrossRef]
- Su, Y.; Zheng, T.; Qian, C. Application potential of Bacillus megaterium encapsulated by low alkaline sulphoaluminate cement in self-healing concrete. Constr. Build. Mater. 2020, 273, 121740. [Google Scholar] [CrossRef]
- Milind, V.M. Performance of polypropylene fibre reinforced concrete. IOSR J. Mech. Civ. Eng. 2015, 12, 28–36. [Google Scholar]
- Nematollahi, B.; Vijay, P.; Sanjayan, J.; Nazari, A.; Xia, M.; Naidu Nerella, V.; Mechtcherine, V. Effect of Polypropylene Fibre Addition on Properties of Geopolymers Made by 3D Printing for Digital Construction. Materials 2018, 11, 2352. [Google Scholar] [CrossRef]
- Quiatchon, P.R.J.; Dollente, I.J.R.; Abulencia, A.B.; Libre, R.G.D.G., Jr.; Villoria, M.B.D.; Guades, E.J.; Promentilla, M.A.B.; Ongpeng, J.M.C. Investigation on the Compressive Strength and Time of Setting of Low-Calcium Fly Ash Geopolymer Paste Using Response Surface Methodology. Polymers 2021, 13, 3461. [Google Scholar] [CrossRef] [PubMed]
- McFarland, J. Nephelometer: An Instrument for Estimating the Number of Bacteria in Suspensions Used for Calculating the Opsonic Index and for Vaccines. J. Am. Med. Assoc. 1907, 14, 1176–1178. [Google Scholar] [CrossRef]
- Leber, A.L. Preparation of Routine Media and Reagents Used in Antimicrobial Susceptibility Testing. In Clinical Microbiology Procedures Handbook; ASM Press: Washington, DC, USA, 2016; pp. 5.20.1.1–5.20.3.10. [Google Scholar]
- ASTM C109/C109M; Standard Test Method for Compressive Strength of Hydraulic Cement Mortars (Using 2-in. or [50-mm] Cube Specimens). ASTM International: West Conshohocken, PA, USA, 2016.
- Sahoo, K.K.; Sathyan, A.K.; Kumari, C.; Sarkar, P.; Davis, R. Investigation of cement mortar incorporating Bacillus sphaericus. Int. J. Smart Nano Mater. 2016, 7, 91–105. [Google Scholar] [CrossRef]
- Nematollahi, B.; Sanjayan, J.; Qiu, J.; Yang, E.-H. Micromechanics-based investigation of a sustainable ambient temperature cured one-part strain hardening geopolymer composite. Constr. Build. Mater. 2017, 131, 552–563. [Google Scholar] [CrossRef]
- Feng, J.; Shunzhi, Q. Accelerating Autonomic Healing of Cementitious Composites by Using Nano Calcium Carbonate Coated Polypropylene Fibers. Mater. Des. 2023, 225, 111549. [Google Scholar] [CrossRef]
- Zhu, H.; Zhang, D.; Wang, T.; Wu, H.; Li, V. Mechanical and Self-healing Behavior of Low Carbon Engineered Cementitious Composites Reinforced With PP-fibers. Constr. Build. Mater. 2020, 259, 119805. [Google Scholar] [CrossRef]
- Ducman, V.; Kramar, S.; Šajna, A. Alkali activated repair mortars based on different precursors. In Eco-Efficient Repair and Rehabilitation of Concrete Infrastructures; Woodhead Publishing: Sawston, UK, 2018; pp. 263–292. [Google Scholar]
- PN-EN 1504-3:2006; Products and Systems for the Protection and Repair of Concrete Structures—Definitions, Requirements, Quality Control and Evaluation of Conformity—Part 3: Structural and Non-Structural Repair. PKN: Warsaw, Poland, 2006.
- ASTM C 597; Standard Test Method for Pulse Velocity through Concrete. American Society for Testing and Materials: West Conshohocken, PA, USA, 2016.
- Borg, R.P.; Baldacchino, O.; Ferrara, L. Early age performance and mechanical characteristics of recycled PET fibre reinforced concrete. Constr. Build. Mater. 2016, 108, 29–47. [Google Scholar] [CrossRef]
- Srivastava, A.; Singh, S.K.; Sharma, C.S. Correlation Between Ultrasonic Pulse Velocity (UPV) and Compressive Strength of Coal Bottom Ash Mortar. J. Inst. Eng. (India) Ser. A 2021, 102, 421–433. [Google Scholar] [CrossRef]
- Sitarz, M.; Hager, I.; Choińska, M. Evolution of Mechanical Properties with Time of Fly-Ash-Based Geopolymer Mortars under the Effect of Granulated Ground Blast Furnace Slag Addition. Energies 2020, 13, 1135. [Google Scholar] [CrossRef]
- Gupta, A.; Gupta, N.; Saxena, K.K. Experimental study of the mechanical and durability properties of Slag and Calcined Clay based geopolymer composite. Adv. Mater. Process. Technol. 2022, 8, 655–669. [Google Scholar] [CrossRef]
- Nath, P.; Sarker, P.K.; Rangan, V.B. Early Age Properties of Low-calcium Fly Ash Geopolymer Concrete Suitable for Ambient Curing. Procedia Eng. 2015, 125, 601–607. [Google Scholar] [CrossRef]
- Yip, C.K.; Lukey, G.C.; Provis, J.L.; van Deventer, J.S.J. Effect of calcium silicate sources on geopolymerisation. Cem. Concr. Res. 2008, 38, 554–564. [Google Scholar] [CrossRef]

| Batch Code | Fly-Ash (g) | Sand (g) | Polypropylene (g) | NaOH (g) | KOH (g) | Na2SiO3 (g) | Water (mL) | Bacteria (Cells/mL) |
|---|---|---|---|---|---|---|---|---|
| PP0 | 1469 | 1039 | 0 | 165 | 55 | 441 | 220 | 0 |
| PP1 | 1469 | 1039 | 36.73 | 165 | 55 | 441 | 220 | 0 |
| PP2 | 1469 | 1039 | 73.45 | 165 | 55 | 441 | 220 | 0 |
| PP3 | 1469 | 1039 | 110.18 | 165 | 55 | 441 | 220 | 0 |
| BP0 | 1469 | 1039 | 0 | 165 | 55 | 441 | 220 | 1.5 × 108 |
| BP1 | 1469 | 1039 | 36.73 | 165 | 55 | 441 | 220 | 1.5 × 108 |
| BP2 | 1469 | 1039 | 73.45 | 165 | 55 | 441 | 220 | 1.5 × 108 |
| BP3 | 1469 | 1039 | 110.18 | 165 | 55 | 441 | 220 | 1.5 × 108 |
| pH | 24 h of Incubation | 7 Days of Incubation | ||||||
|---|---|---|---|---|---|---|---|---|
| B. megaterium | B. subtilis | B. megaterium | B. subtilis | |||||
| 37 °C | 50 °C | 37 °C | 50 °C | 37 °C | 50 °C | 37 °C | 50 °C | |
| 8 | G | N/G | G | G | G | G | G | G |
| 9 | G | N/G | G | N/G | G | G | G | G |
| 10 | N/G | N/G | N/G | N/G | G | G | G | G |
| 11 | N/G | N/G | N/G | N/G | G | G | G | G |
| 12 | N/G | N/G | N/G | N/G | G | G | G | G |
| 13 | N/G | N/G | N/G | N/G | G | G | G | G |
| 14 | N/G | N/G | N/G | N/G | G | G | G | G |
| ANOVA | ||||||
|---|---|---|---|---|---|---|
| Source of Variation | SS | df | MS | F | p-Value | F Crit |
| Bacteria | 773.6162 | 1 | 773.6162 | 64.83539 | 5.1 × 10−7 | 4.493998 |
| PP | 150.0091 | 3 | 50.00304 | 4.190666 | 0.022846 | 3.238872 |
| Interaction | 23.33088 | 3 | 7.776959 | 0.651773 | 0.593333 | 3.238872 |
| Within | 190.9121 | 16 | 11.932 | |||
| Total | 1137.868 | 23 |
| Batch Code | UPV after Cracking, V1 (m/s) | UPV before Cracking, V2 (m/s) | UPV after Healing, V3 (m/s) | Damage Degree, DD (%) | Self-Healing, H (%) |
|---|---|---|---|---|---|
| PP0 (0%) | 1672 ± 866.12 | 2736.33 ± 356.82 | 1637.33 ± 481.83 | 38.61 ± 32.23 | −38.66 ± 23.49 |
| PP1 (0.25%) | 1980 ± 485.01 | 2591.33 ± 603.70 | 1789.33 ± 709.03 | 19.78 ± 32.65 | −28.43 ± 36.38 |
| PP2 (0.5%) | 1671 ± 88.66 | 2161 ± 109.90 | 1761.33 ± 98.29 | 22.63 ± 3.77 | −18.50 ± 1.31 |
| PP3 (0.75% PP) | 817.33 ± 36.43 | 2503 ± 274.43 | 2186 ± 100.02 | 67.20 ± 2.75 | −12.05 ± 11.19 |
| BP0 (0%) | 951.33 ± 753.72 | 1187.67 ± 148.78 | 1365.33 ± 753.14 | 20.47 ± 57.92 | 16.77 ± 67.99 |
| BP1 (0.25%) | 288.33 ± 268.95 | 686.33 ± 147.81 | 1677.33 ± 245.59 | 58.36 ± 37.62 | 147.18 ± 32.0 |
| BP2 (0.5%) | 1695.33 ± 370.91 | 1794.67 ± 195.78 | 2281.67 ± 262.53 | 4.21 ± 29.60 | 28.77 ± 28.76 |
| BP3 (0.75% PP) | 1634.67 ± 193.40 | 1261.67 ± 489.36 | 2234 ± 148.68 | −39.94 ± 53.96 | 90 ± 65.49 |
| Specimen Code | Ca | Si | Fe | K | Ti | Rh | Sr |
|---|---|---|---|---|---|---|---|
| PP3 | 78.84 | -- | 14.71 | 2.74 | 1.31 | 0.99 | 0.72 |
| BP3 | 56.11 | 19.74 | 16.58 | 3.55 | 1.75 | 0.85 | -- |
Disclaimer/Publisher’s Note: The statements, opinions and data contained in all publications are solely those of the individual author(s) and contributor(s) and not of MDPI and/or the editor(s). MDPI and/or the editor(s) disclaim responsibility for any injury to people or property resulting from any ideas, methods, instructions or products referred to in the content. |
© 2023 by the authors. Licensee MDPI, Basel, Switzerland. This article is an open access article distributed under the terms and conditions of the Creative Commons Attribution (CC BY) license (https://creativecommons.org/licenses/by/4.0/).
Share and Cite
Griño, A.A., Jr.; Soriano, H.S.P.; Promentilla, M.A.B.; Ongpeng, J.M.C. Exploring the Potential of Polypropylene Fibers and Bacterial Co-Culture in Repairing and Strengthening Geopolymer-Based Construction Materials. Buildings 2023, 13, 2668. https://doi.org/10.3390/buildings13102668
Griño AA Jr., Soriano HSP, Promentilla MAB, Ongpeng JMC. Exploring the Potential of Polypropylene Fibers and Bacterial Co-Culture in Repairing and Strengthening Geopolymer-Based Construction Materials. Buildings. 2023; 13(10):2668. https://doi.org/10.3390/buildings13102668
Chicago/Turabian StyleGriño, Albert A., Jr., Hannah Shane P. Soriano, Michael Angelo B. Promentilla, and Jason Maximino C. Ongpeng. 2023. "Exploring the Potential of Polypropylene Fibers and Bacterial Co-Culture in Repairing and Strengthening Geopolymer-Based Construction Materials" Buildings 13, no. 10: 2668. https://doi.org/10.3390/buildings13102668
APA StyleGriño, A. A., Jr., Soriano, H. S. P., Promentilla, M. A. B., & Ongpeng, J. M. C. (2023). Exploring the Potential of Polypropylene Fibers and Bacterial Co-Culture in Repairing and Strengthening Geopolymer-Based Construction Materials. Buildings, 13(10), 2668. https://doi.org/10.3390/buildings13102668

